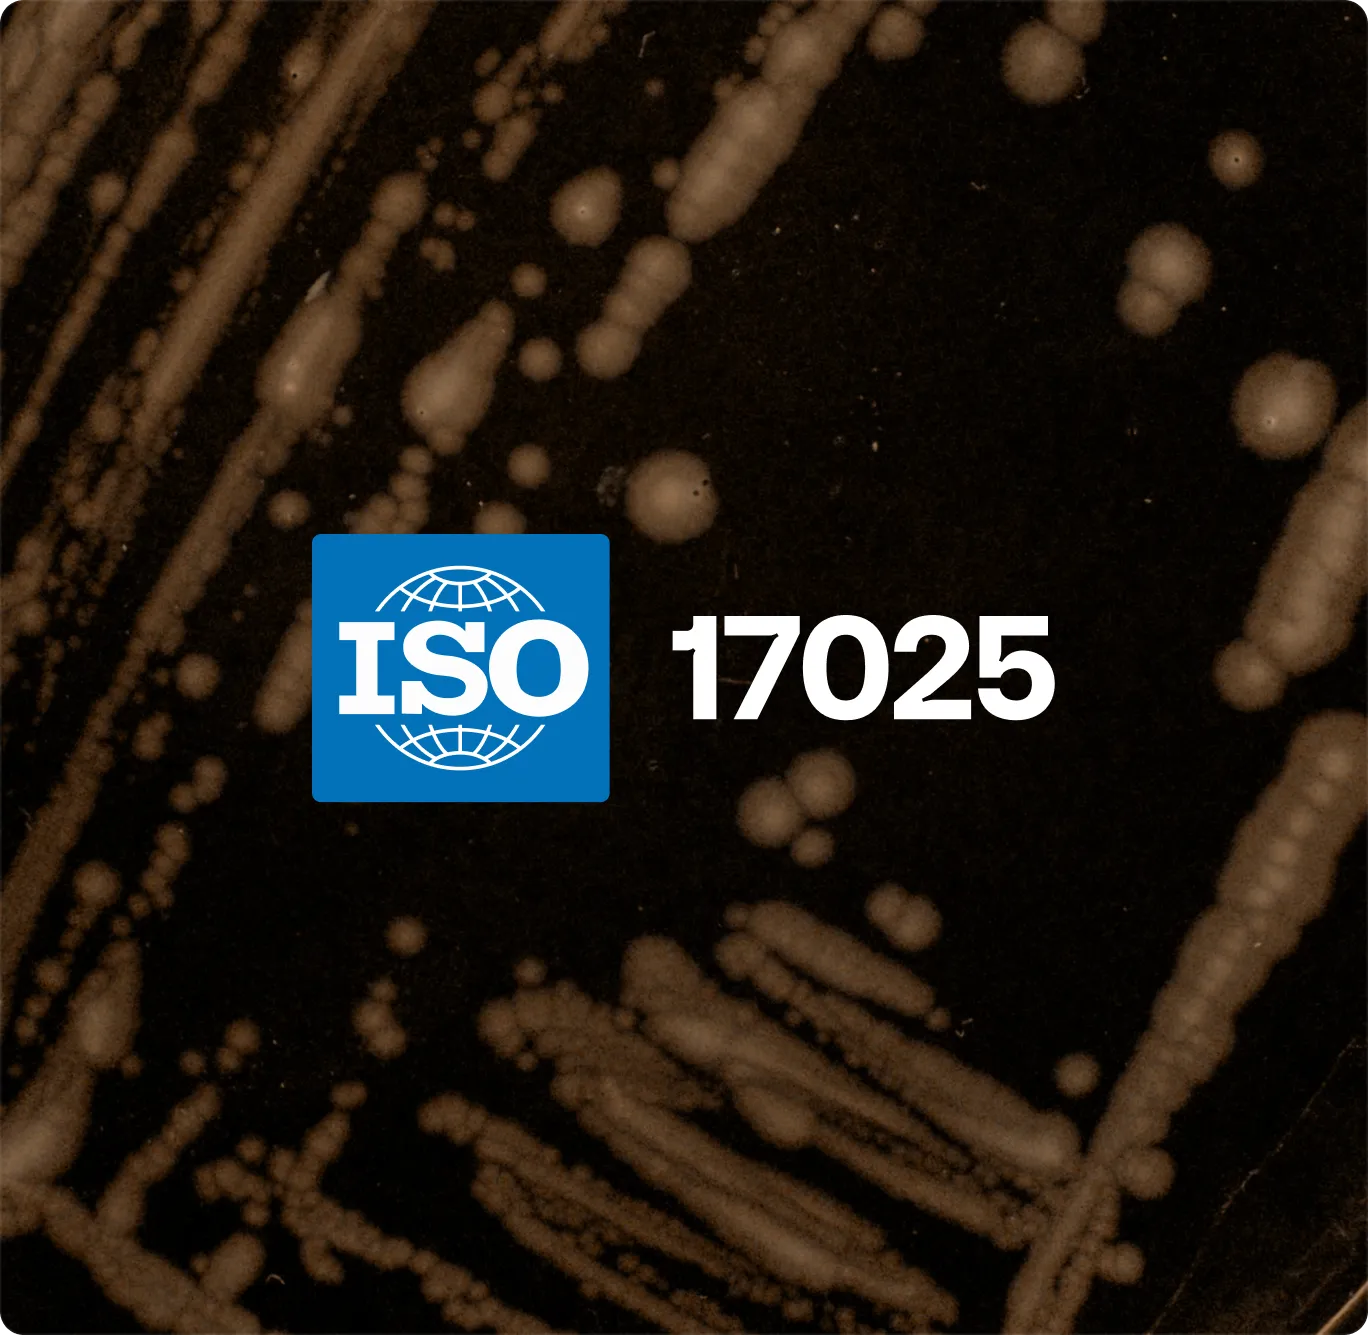

Trust Center
On this page, you'll quickly be able to answer key questions when it comes to quality management, compliance, methods and support. If you're not able to find what you need here, please send an email to quality@reshapebiotech.com with your questions.
SOC 2 Type II attested
Reshape is committed to information security and is compliant with global information security standards, making it simple to adopt and conforming to enterprise requirements for data processing.

ISO27001 certified
We have been audited for ISO 27001, demonstrating enterprise-grade security validated by independent auditors. Our information security system meets globally recognized standards.

Streamline your ISO17025 compliance
The Reshape platform can greatly streamline your laboratory quality management, providing extensive digital trails at a detailed level of all samples. We make it simple to integrate with your existing quality management system and getting ISO17025 accredited.

A solution your IT team will embrace
We make it simple for your IT team to manage and configure our solution at scale without needing access to your internal networks. Our dedicated technical support team is also ready to directly support implementations.

Applications
Detailed application notes to quickly get up and running with new assays
Our application teams are continuously working on developing our applications and characterizing our systems. As part of this, we consolidate a range of common assay types with detailed application notes that you can utilize to hit the ground running.
All ApplicationsTotal viable count
Quantify microbial load by counting colony-forming units.


Differential counts
Count colony-forming units for different types of cells and colonies (based on morphology, color, or size).


Growth kinetics
Track microbial growth dynamics over time.


Insects health
Measure insect life-stage parameters like hatchability, growth rates, pupation, eclosion, and mortality.


Fluorescence
Detect and quantify recombinant GFP/RFP strains and their expression levels.
.png)
.png)
Colorimetric
Monitor pH, metabolic activity, or growth via color change.


Technical documentation
Science can get complex quickly. To help make it easier, we’ve gathered papers on technical topics that will help you quickly verify that your assays perform as expected and to help mitigate any issues you might encounter.
The perfect companion for standardization
Reshape is a contributor to several ISO working groups including ISO/TC 34 and DS/S-436, where we work with other global experts to develop and standardize the application of machine learning in microbiology.
Our platform is compatible with a wide range of methods spanning total enumeration, growth quantification and detection of specific organisms.
- ISO4833-1/2 and ISO6222 - Enumeration of microorganisms
- ISO11290 - Listeria Monocytogenes
- ISO6579 - Salmonella
- ISO16654 - E. Coli 0157
- ISO21528 - Enterobacteriaceae
- ISO6888 - Staphylococcus Aureus (coagulase-positive)
- ASTM D5590-17
Enterprise grade customer support
Our dedicated support team cover our global customer base with efficient issue resolution for any type of issue. Additionally, we maintain an infrastructure uptime monitoring service.

Publications database
We love research and researchers, and through our academic program work with leading institutions worldwide. Find publications that utilize our platform here:



